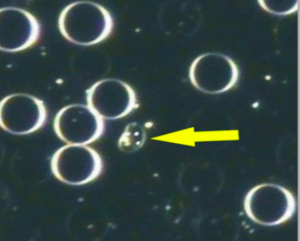

Thecits appear as small spheres, varying in size from very small to the size of a RBC, containing 2 to 9 nuclei. Chondro-thecits contain more than 9 nuclei.
Appearance
Thecits appear as small spheres, varying in size from very small to the size of a RBC, containing 2 to 9 nuclei. Chondro-thecits contain more than 9 nuclei.
Short Description
Colloid thecits: appear as small spheres that do not have any nuclei, hair-like growths or any other protuberances. Their function is to produce and release colloids as part of the system’s defence mechanism.
Mychits: the bacterial form that progresses from the colloid thecit. It appears as a sphere with one stationary nucleus in the cell wall. Mychits can also arrange themselves into chains, called mychit chains or desme. Mychits are formed when a symprotit arranges nutritional reserves around it to create a cell.
Pleomorphic Perspective
Thecits are primal forms of bacterial cells that can develop into bacterial rods and ascits. Chondro-thecits will develop into synascits in anaerobic conditions and are associated with fermentative conditions. Pleomorphic bacterial forms develop from the symprotit, when it arranges nutritional reserves around it to create a cell (termed a mychit). The mychit’s nucleus can enlarge, forming a cystit; or the nucleus can divide, creating a thecit. The mychit can also then stretch and its nucleus then divides into two, which then arrange themselves at the two opposite poles, forming a rod-form bacterium, from which an ascit can develop.
Implications
- The presence of these primitive bacterial forms is an indication of dysbiosis and chronic disease.
- They may not be visible initially and only start appearing after some time.
- They are associated with chronic disease, dental foci and tumours.
- Thecits, when viewed in brightfield, will appear as fermentation. This anomaly has been linked to Candida overgrowth and possible leaky gut syndrome (see “Fermentation”).